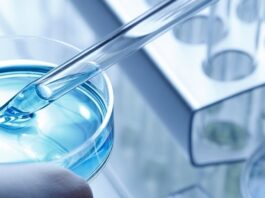

La lassità cutanea del corpo è un inestetismo molto comune, un problema sentito ma dal bisogno ancora latente e inespresso. Mentre per il viso le pazienti sanno cosa vogliono e agiscono in un’ottica di prevenzione e mantenimento, per il corpo ad esclusione di inestetismi molto noti come la cellulite, si fa fatica a orientarsi, si pensa non ci possa essere soluzione e si agisce per correggere un problema già evidente, in vista dell’urgenza estiva. Il risultato è che il tempo dedicato al corpo è del 20% contro l’80% per il viso. Oggi la salute della cute è centrale, tanto per il viso, quanto per il corpo, ed è importante che la paziente sia adeguatamente informata sui risultati che la medicina estetica offre in termini di prevenzione e di cura, per ridurre l’effetto dell’invecchiamento; ecco perché la ricerca e l’innovazione tecnologica possono giocare un ruolo fondamentale nel ribilanciare queste percentuali. IBSA Derma forte della propria expertise nel campo della medicina estetica e nella produzione di acido ialuronico ultrapure valorizza la bellezza del corpo, pari a quella del viso, proponendo il suo acido ialuronico ibrido basato su tecnologia brevettata. Con approccio serio e scientifico ha sviluppato la nuova scala fotografica della lassità.
IBSA Derma e la scala fotografica della lassità IBSA Derma ha ideato la scala fotografica della lassità dedicata all’interno braccia, la novità del 2022: lo strumento utile per il dialogo medico-paziente per comprendere meglio a quale livello di lassità può corrispondere il proprio interno braccia e quindi calibrare le aspettative. Questa scala è stata validata attraverso un rigoroso processo scientifico che ha visto la collaborazione di autorevoli esperti del settore; processo che ha portato alla pubblicazione della stessa in un’autorevole rivista scientifica “Clinical, Cosmetic and Investigational Dermatology”.
“Nella valutazione sul tipo di trattamento da fare, una delle cose più importanti è calibrare l’aspettativa correttamente. Le possibilità per far fronte alla lassità cutanea del corpo sono diverse; senza dubbio la chirurgia resta il principale strumento su elevato grado di lassità. Ma quando la lassità è meno severa si può ricorrere all’utilizzo di energy devices o prodotti iniettivi. Anche in ottica di prevenzione considero particolarmente interessanti i complessi ibridi cooperativi di acido ialuronico, un trattamento iniettivo che nella mia esperienza clinica consente di raggiungere risultati progressivi in tempi rapidi. Con il nuovo trattamento specifico per il corpo possiamo andare incontro alle aspettative delle pazienti migliorando la skin quality in modo efficace”, ha dichiarato Antonello Tateo, Specialista in Chirurgia Plastica Estetica e Ricostruttiva.
“È il rigore scientifico di IBSA Derma che ha permesso di individuare e brevettare una nuova forma di acido ialuronico, una forma ibrida supportata da studi clinici che ne hanno convalidato l’effetto su lassità e rugosità lieve-moderata; colmando così un vuoto d’offerta anche nel segmento corpo. Un grande contributo alla missione di IBSA Derma di far emergere la bellezza autentica della persona con trattamenti rispettosi dei tessuti, volti a preservare e ripristinare e non a stravolgere”, ha evidenziato Gilberto Bellia, Head of Medical Affairs, IBSA Farmaceutici.
“Mettere al centro la persona è uno dei valori che IBSA porta avanti in tutte le aree in cui è attiva. Attraverso il concetto “Ognuno di voi è un capolavoro” intende ripristinare l‘autentica bellezza della pelle, valorizzare capolavori proprio come la cornice in un quadro. Con questo approccio partono tutte le nostre iniziative e campagne di comunicazione. Il Manifesto Body rende esplicita la volontà di promuovere una cura maggiore del corpo incoraggiando le donne a svelare la propria bellezza attraverso ogni dettaglio del proprio corpo”, ha dichiarato Giulia Drei, PR & Communication Officer di IBSA Farmaceutici – Dermoaesthetic Department.